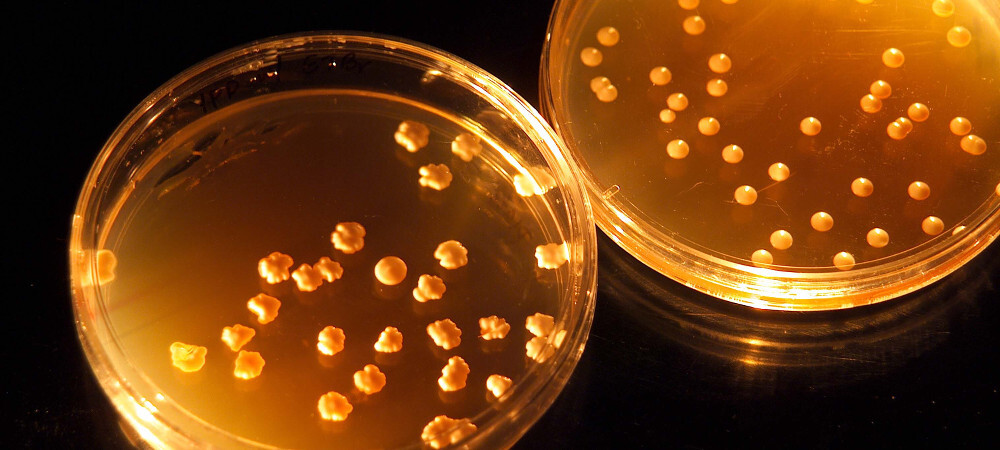
nasa laboratorio

sls-nasa-1
La NASA quiere que los astronautas del futuro usen sus desechos para comer
La NASA se está planteando que una solución para llegar más lejos en el espacio es comer deshechos humanos.
Noticias relacionadas
Comer deshechos humanos puede ser la única manera de sobrevivir a los largos viajes en el espacio.
Conseguir comida en el espacio es bastante difícil, así que los astronautas se la tienen que llevar consigo en la nave y recibir provisiones de manera periódica.
Esto es posible cuando hablamos de la Estación Espacial Internacional, por ejemplo, pero no cuando tratamos con viajes mucho más largos que requieren llevar mucho más peso (y por lo tanto más combustible).
Los astronautas puede que tengan que comer deshechos humanos
La NASA es muy consciente de este problema de cara a futuros viajes en los que el ser humano llegará a otros planetas del sistema solar como Marte, y por eso quiere investigar una solución.
No es el único problema que busca alguna innovación similar; la NASA ha seleccionado ocho proyectos de universidades de EEUU relacionados de alguna manera con la exploración espacial, y la comida es sólo uno de ellos.
nasa laboratorio
Por ejemplo, uno de los proyectos consiste en el estudio del uso de microbios para convertir atmósferas tóxicas para el ser humano en zonas habitables; algo útil por ejemplo para crear colonias que puedan autoabastecerse.
Pero el que más destaca es un proyecto de la Universidad de Clemson orientado a reciclar los deshechos humanos para convertirlos en comida, productos nutracéuticos y en materiales. Dicho de otra manera, la NASA quiere que los astronautas se beban su orina y se coman sus heces, después de tratarlas, por supuesto.
El equipo recibirá 200.000 dólares cada año para llevar adelante su investigación durante los próximos tres años. Aunque suena asqueroso, puede que en los viajes largos esta sea la única solución para comer.



